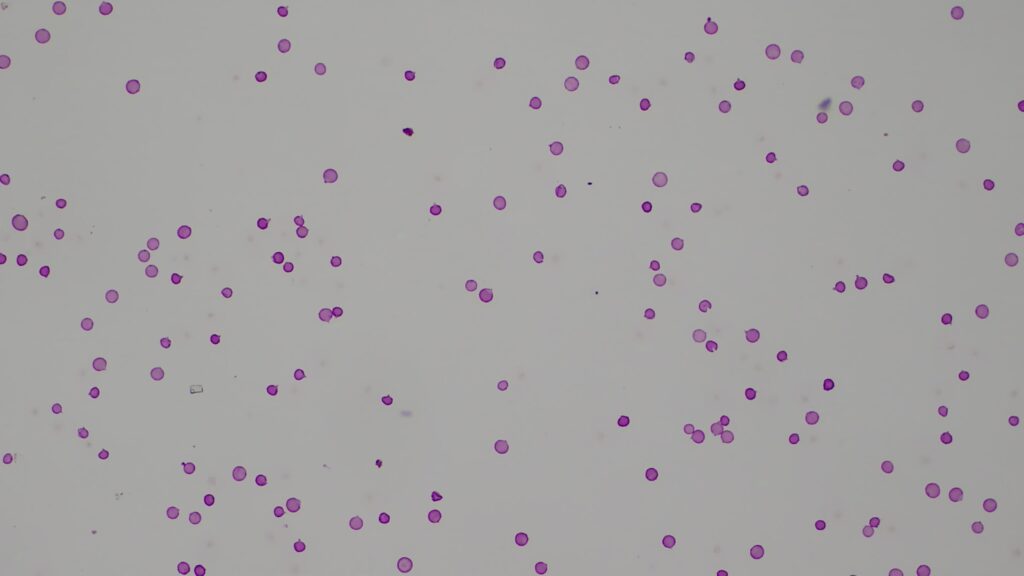

観測史上最高値
耳鼻咽喉科 本田医師からのご報告を紹介いたします。
当院屋上にて、2022年からスギ花粉の飛散数を測定しています。
本年3月20日、2428個/cm2と観測史上最高値を記録しました。
本年は非常にスギ花粉飛散数が多い年となっております。今月末まで大量の飛散が続くと予想されます。
今まで花粉症の症状がなかった方でも発症するリスクがあります。
できるだけ外出は避け、外出する際は花粉の暴露を防ぐマスク、めがねによる防御対策をおすすめいたします。
写真:3月20日の測定結果顕微鏡写真。ピンクの球形粒子がスギ花粉。

連絡先を知りたい
連絡先を知りたい  診療スケジュールを見たい
診療スケジュールを見たい  行き方を知りたい
行き方を知りたい  救急外来を受診したい
救急外来を受診したい  これからご入院される方へ
これからご入院される方へ  里帰り出産について知りたい
里帰り出産について知りたい  患者さんを紹介したい
患者さんを紹介したい